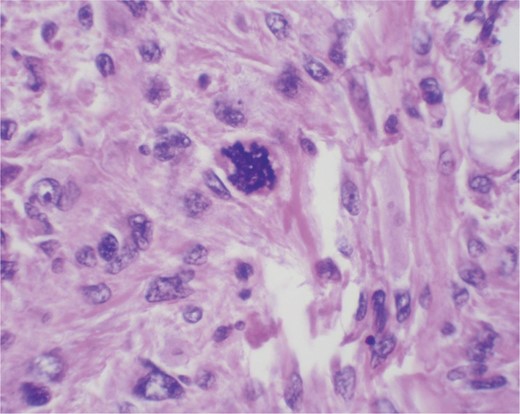
High power. Bizarre nuclei. High mitotic activity.

-
PDF
- Split View
-
Views
-
Cite
Cite
Parker Bassett, Jamaal Shaban, Ilmana Fulger, Bert Petersen, Twenty-year-old female with leiomyosarcoma of the breast, Journal of Surgical Case Reports, Volume 2014, Issue 1, January 2014, rjt121, https://doi.org/10.1093/jscr/rjt121
Close - Share Icon Share
Abstract
Primary leiomyosarcoma is a disease with <50 documented cases in the literature worldwide. The standard of care for these tumors has not been established. Physicians who have seen these cases in the past have used wide local excision with or without adjunctive chemo-radiation therapy. We review the literature concerning the mainstay of treatment as well as present a new case of an adolescent with primary leiomyosarcoma.
INTRODUCTION
Breast cancer is the leading cancer diagnosed in women today. Of the 12.5% of women diagnosed with malignant breast cancer in the USA, stromal sarcomas represent 1% of all malignant breast cancers [1]. A review of the literature illustrates that <50 cases have been documented worldwide [2]. This case report reviews the literature with emphasis on current treatment modalities.
CASE REPORT
A 20-year-old female with a history of neurofibromatosis, and left breast supernumerary nipple excision presented to her primary care physician, after noticing a lump in her left breast at the site of her previous surgical scar after accidentally bumping her breast in January 2012. Her primary care physician then referred her to the breast surgery clinic at St. Barnabas Hospital. She was seen and examined at the breast clinic, where a palpable firm 1 × 1 cm mass was identified at the 6 O'clock position. She denied any nipple discharge. The decision was made to obtain an ultrasound (seen in Fig. 1) with close follow-up in the breast surgery clinic.

She returned to clinic later in January after the ultrasound, which revealed a 1.4 × 0.9 × 1.8 cm fluid collection at the 6 O'clock position most likely representing a hematoma; BIRADS #3 likely benign recommend short-term follow-up. She was scheduled for a repeat ultrasound in April 2012 with follow-up in breast clinic following the ultrasound. Repeat ultrasound (seen in Fig. 2) revealed a stable fluid collection measuring 1.5 × 1.2 × 2.2 cm, once again BIRADS #3 likely benign recommend short-term follow-up with the breast surgeon. She was seen in clinic following the ultrasound in April and reported decreasing pain and no nipple discharge, she was given a 1-month follow-up appointment.

The patient's pain returned prior to her scheduled appointment, thus she went to the emergency room. The emergency room physician noted a 2-cm sub-areolar mass. She was discharged from the emergency room and given follow-up in the breast surgery clinic.
She was seen and evaluated in the breast surgery clinic following her emergency room visit. In the breast clinic the mass was noted to be 2.5 cm on examination. She denied any further pain and so a 1-month follow-up was given again. She returned to breast clinic 1 month later in May 2012 where the mass was noted to be 3 cm. Due to increasing size and persistence of the mass, she was scheduled for excisional biopsy.
The excisional biopsy was performed in June 2012, which revealed a diagnosis of leiomyosarcoma (slides seen in Figs. 3–5).

Cross section at low power. Intersecting bundles. Multinucleated giant cell in the bottom right.

Immunostain with SMA (smooth muscle actin). Positive cytoplasmic staining indicating smooth muscle origin.
She followed-up in the breast surgery clinic and was notified of the diagnosis. The patient was then scheduled for total mastectomy with axillary lymph node dissection of the left breast with tissue expander placement by the plastic surgery team. The specimen was again sent for pathology, which revealed residual leiomyosarcoma with no lymphovascular invasion, margins negative for sarcoma and sentinel lymph node biopsy negative for sarcoma.
DISCUSSION
Primary leiomyosarcoma of the breast is rare and uncommon breast tumor [3]. The first reported case was by Waterworth in 1968 [4]. Since that time <50 cases have been reported worldwide [2]. Most cases occur in postmenopausal women between the fifth and seventh decades; however increasing the number of reports of premenopausal primary sarcomas is being reported, including the one found in our patient [2, 5]. The origin of the malignant cell has been debated; smooth muscle cells from blood vessels and myofibroblasts from the nipple areola complex have both been cited as culprits [6, 7].
Treatment in our patient's case was excisional biopsy followed by mastectomy with axillary lymph node biopsy. The mainstay of treatment has been wide local excision, but due to the rarity of the disease no standard of care has been established. Axillary dissection, radiation and chemotherapy all have been used but there is no evidence that they decreased recurrence or mortality [3].
In conclusion, leiomyosarcoma is an infrequent disease of the breast that can be very difficult to diagnose preoperatively. The cancer has been treated as other sarcomas are treated: with wide local excision and adjunctive chemo-radiation therapy. Axillary lymph node dissection has been performed in many of the cases but there is no evidence that outcomes are changed. Further research into the pathophysiology of this disease as well as treatment modalities is needed.